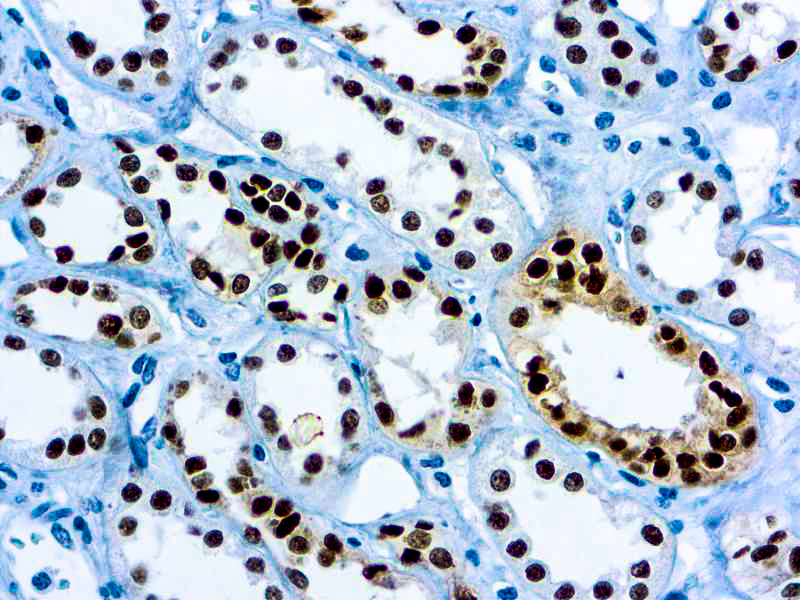

PAX-8
Description
PAX 8 is expressed in a high percentage of renal cell carcinomas and ovarian cancers. This mouse monoclonal PAX 8 antibody [4H7B3] has been designed to target restricted epitopes, and exhibits higher specificity and provides sharper staining than the PAX 8 rabbit polyclonal antibody. Unlike the polyclonal PAX 8, this mouse monoclonal antibody does not stain B-cells, and does not recognize epitopes of pancreatic origin and neuroendocrine cells in stomach and colon; thus providing superior specificity. The expression of the mouse monoclonal PAX 8 targets antigens found in normal kidney, thyroid and cervix, but not normal ovary. PAX 8 stains nuclei exclusively and performs well in formalin-fixed paraffin-embedded tissues.
Additional information
| Catalog No. | PDM180 Prediluted |
|---|---|
| Clone | 4H7B3 |
| Isotype | IgG1 |
| Immunogen | ag0306 |
| Species | Mouse |
| Cellular Localization | Nuclear |
| Positive Control Tissue | Normal kidney, or serous ovarian carcinomas, renal cell |
| Pretreatment | EDTA Buffer pH 8.0 |
| Incubation & Temperature | 30 min @ RT |
| Intended Use | IVD |
| Detection System | PolyVue Plus – Two Step Detection System or Montage PolyVue Plus Auto Detection System for Montage 360 System |
| Description/Type | Mouse Monoclonal Antibody |
| Format | This product is supplied as a tissue culture supernatant and contains sodium azide as a preservative. |
DATASHEETS & SDS
DATASHEETS & SDS
| Download Datasheet |
| Download SDS Sheet – OSHA |
REFERENCES
REFERENCES
- Lotan TL et al. Am J Surg Pathol. 2009 Jul; 33(7):1037-41.
- Viktorová T et al. Diagn Cytopathol. 2008 Aug; 36(8):568-73.
- Narlis M et al. J Am Soc Nephrol. 2007 Apr; 18(4):1121-9.
Reviews (0)
Only logged in customers who have purchased this product may leave a review.

Reviews
There are no reviews yet.